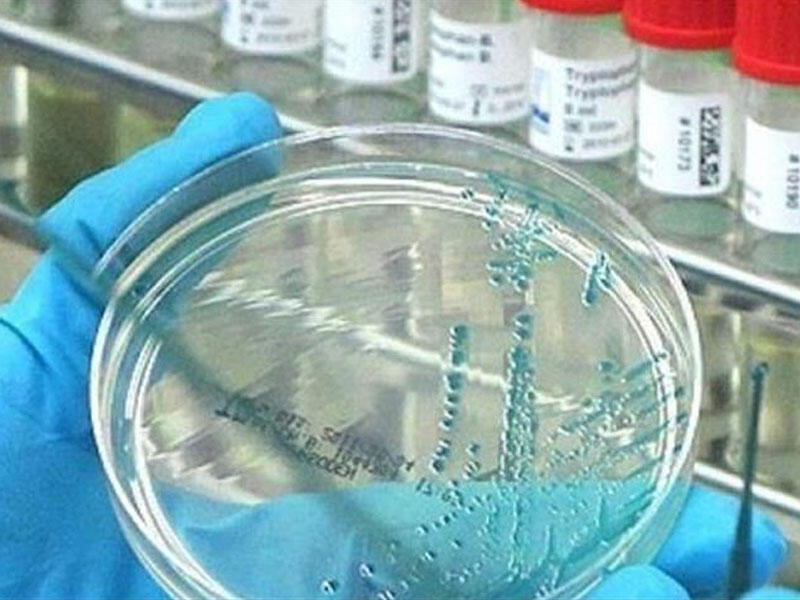
Koronanın mənşəyi ilə bağlı hesabat hazırlandı

Amerikalı ekspertlərin koronavirusun mənşəyi ilə bağlı araşdırma hesabatı 24 avqustda ABŞ Prezidenti Co Baydenə təqdim ediləcək.
7News.Az Axar.az-a istinadən xəbər verir ki, bu barədə Ağ Evin rəsmi nümayəndəsi Cen Psaki bildirib.
Onun sözlərinə görə, hesabat dövlət başçısına təqdim edildikdən bir neçə gün sonra mümkündür ki, ictimaiyyətə açıqlansın.
7News.Az